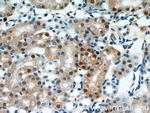
PAX8 Antibody in Immunohistochemistry (Paraffin) (IHC (P))
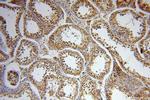
PAX8 Antibody in Immunohistochemistry (Paraffin) (IHC (P))

Search
Proteintech
PAX8 Polyclonal Antibody
{{$productOrderCtrl.translations['antibody.pdp.commerceCard.promotion.promotions']}}
{{$productOrderCtrl.translations['antibody.pdp.commerceCard.promotion.viewpromo']}}
{{$productOrderCtrl.translations['antibody.pdp.commerceCard.promotion.promocode']}}: {{promo.promoCode}} {{promo.promoTitle}} {{promo.promoDescription}}. {{$productOrderCtrl.translations['antibody.pdp.commerceCard.promotion.learnmore']}}
产品信息
10336-1-AP
种属反应
已发表种属
宿主/亚型
分类
类型
抗原
偶联物
形式
浓度
规格
纯化类型
保存液
内含物
保存条件
运输条件
产品详细信息
This antibody can detect all 5 isoforms of PAX8 (31 kDa, 34 kDa, 41 kDa, 43 kDa, and 48 kDa). A 58-60 kDa form has also been reported. Proteintech's 10336-1-AP antibody has cross-reactivities with the other PAX family members.
靶标信息
This gene encodes a member of the paired box family of transcription factors. Members of this gene family typically encode proteins that contain a paired box domain, an octapeptide, and a paired-type homeodomain. This nuclear protein is involved in thyroid follicular cell development and expression of thyroid-specific genes. Mutations in this gene have been associated with thyroid dysgenesis, thyroid follicular carcinomas and atypical follicular thyroid adenomas. Alternatively spliced transcript variants encoding different isoforms have been described.
仅用于科研。不用于诊断过程。未经明确授权不得转售。
生物信息学
蛋白别名: HGNC:8622; paired box gene 8; Paired box protein Pax-8; paired domain gene 8; paired-box-protein; Pax-8 protein; PAX8d; PAX8e; PAX8F; unnamed protein product
基因别名: PAX-8; PAX8
UniProt ID: (Human) Q06710, (Mouse) Q00288, (Rat) P51974
Entrez Gene ID: (Human) 7849, (Mouse) 18510, (Rat) 81819